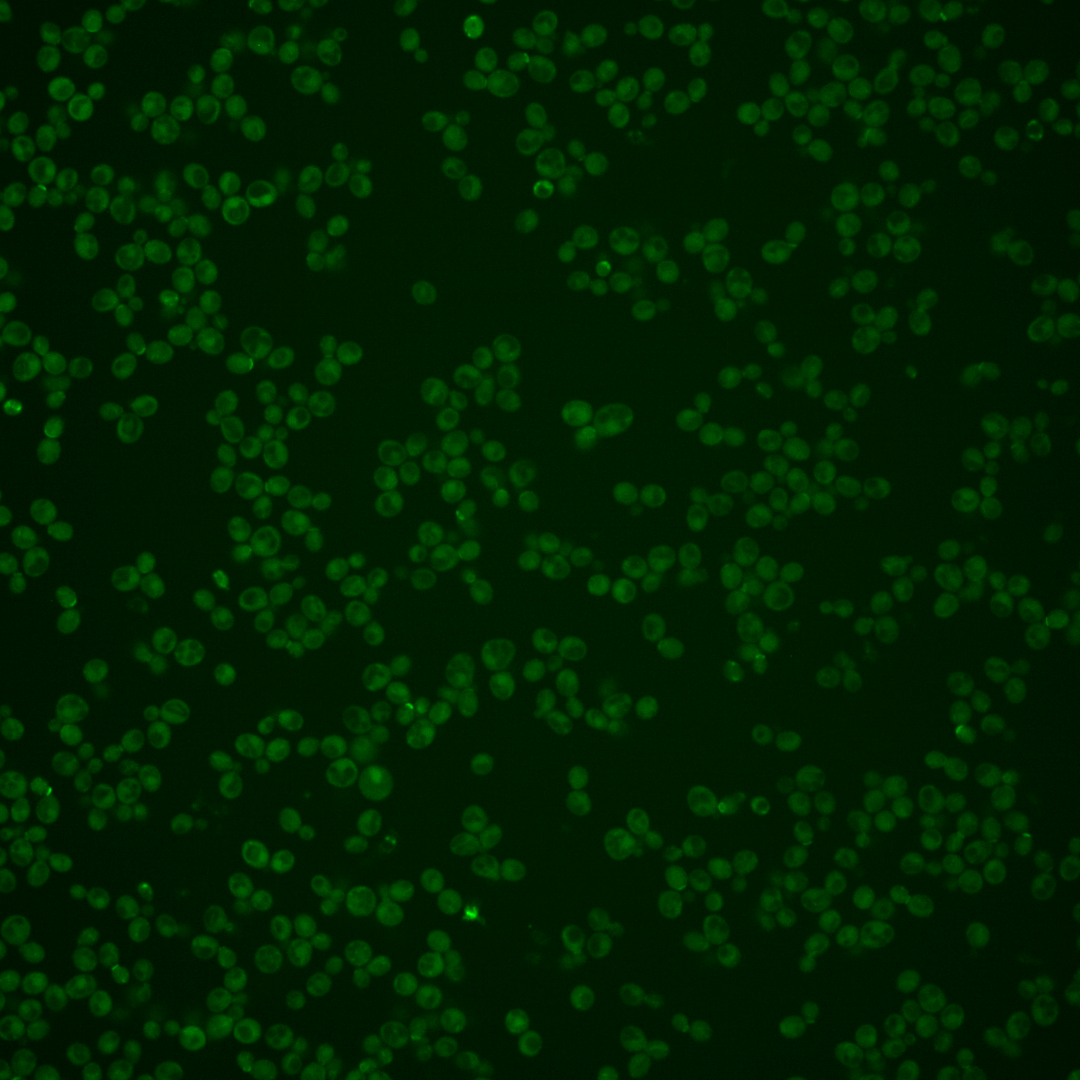
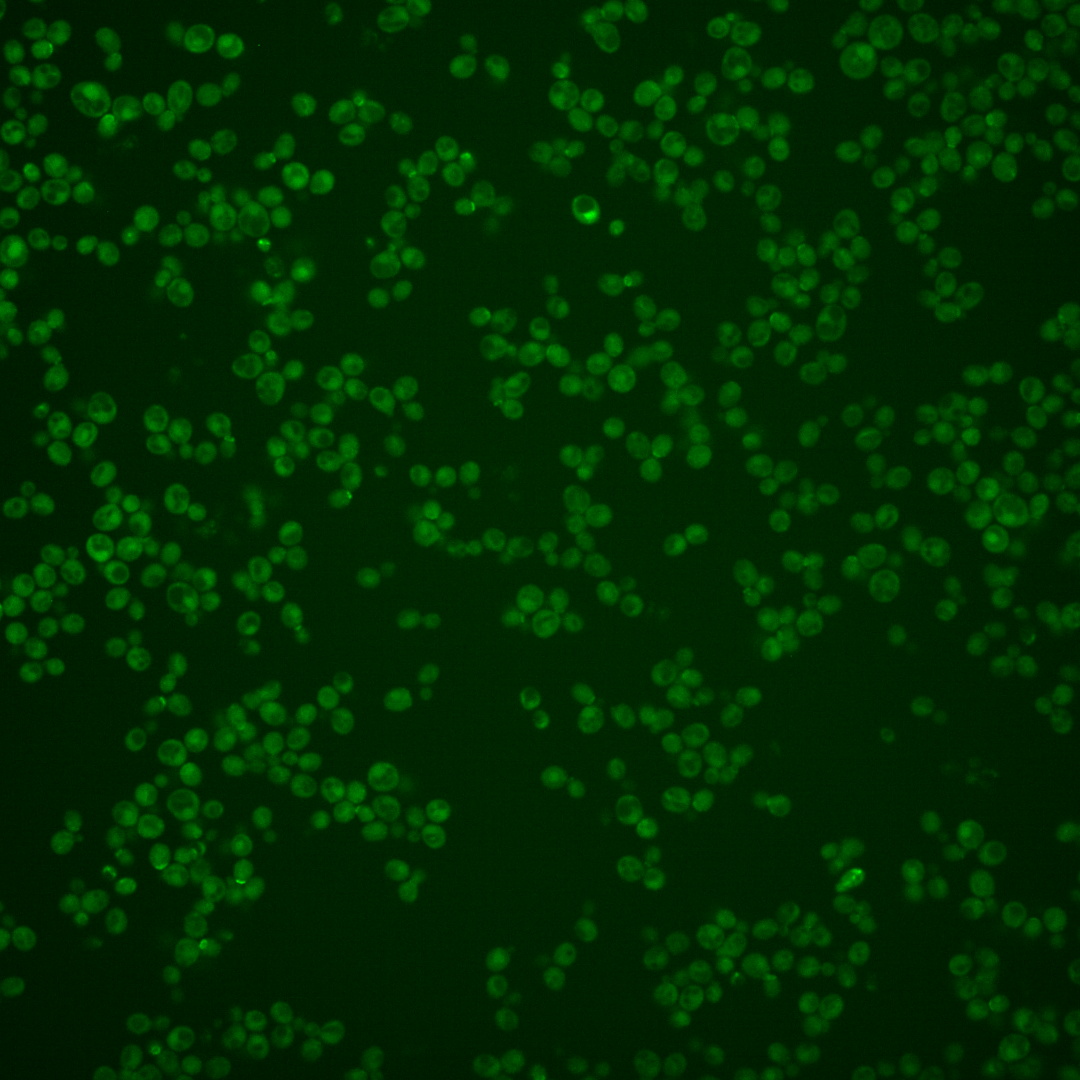
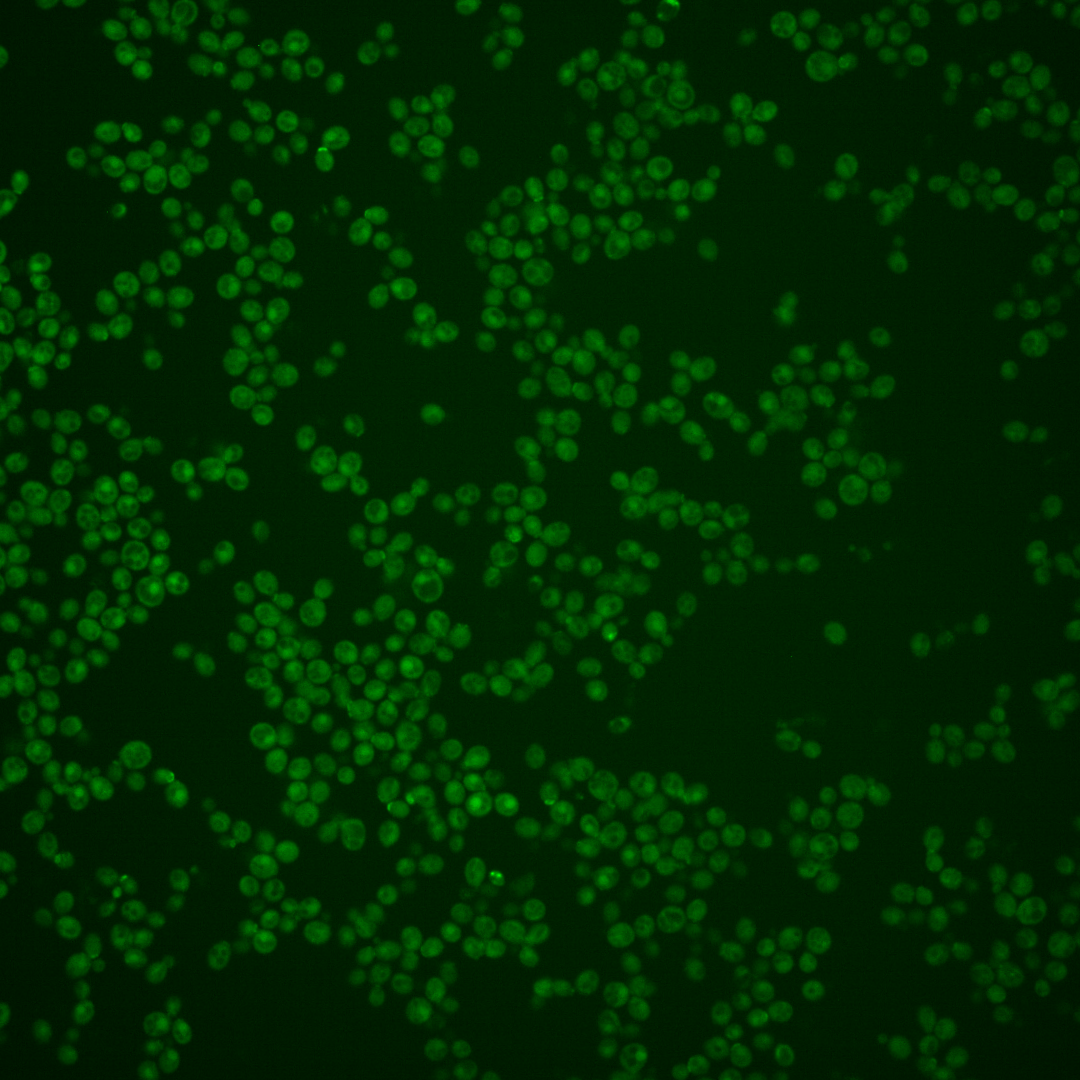
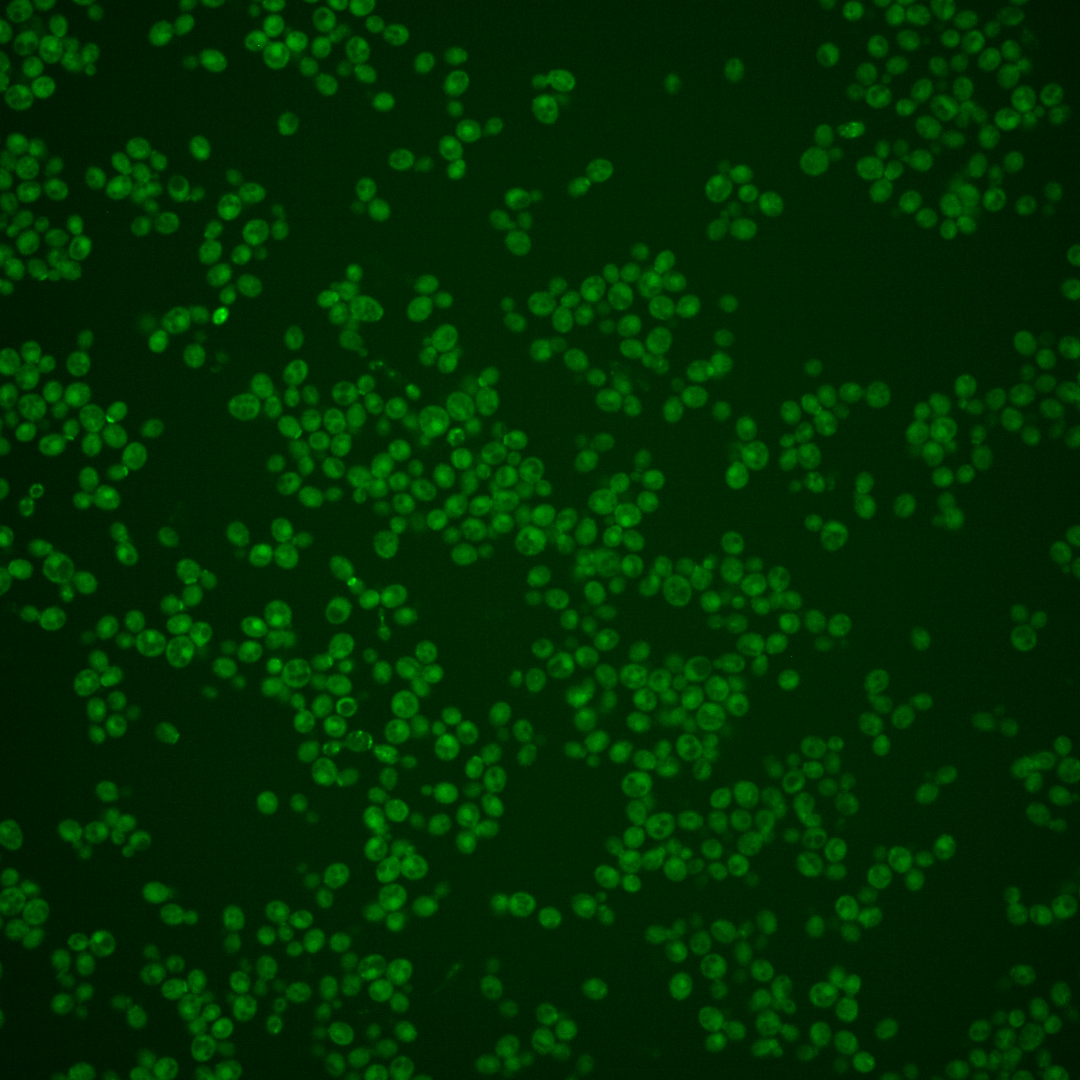

| Standard name | |
|---|---|
| Human Ortholog | |
| Description | Daughter cell-specific secreted protein with similarity to glucanases; degrades cell wall from the daughter side causing daughter to separate from mother |
Micrographs




















































































Sub-cellular Localization
Yeast GFP Assignment
Protein Abundance
Localization Change
External localization resources
| ensLOC | DeepLoc | |||||||||||||||||||||||
|---|---|---|---|---|---|---|---|---|---|---|---|---|---|---|---|---|---|---|---|---|---|---|---|---|
| Localization | WT1 | WT2 | WT3 | RAP60 | RAP140 | RAP220 | RAP300 | RAP380 | RAP460 | RAP540 | RAP620 | RAP700 | HU80 | HU120 | HU160 | rpd3Δ_1 | rpd3Δ_2 | rpd3Δ_3 | WT1 | WT2 | WT3 | AF100 | AF140 | AF180 |
| Cortical Patches | 4 | 2 | 0 | 1 | 2 | 0 | 2 | 1 | 0 | 1 | 0 | 0 | 7 | 2 | 0 | 1 | 0 | 0 | 2 | 13 | 4 | 8 | 20 | 11 |
| Bud | 1 | 4 | 3 | 0 | 5 | 3 | 4 | 6 | 5 | 3 | 4 | 4 | 3 | 1 | 0 | 0 | 1 | 0 | 3 | 15 | 1 | 11 | 10 | 7 |
| Bud Neck | 0 | 4 | 4 | 1 | 0 | 0 | 1 | 6 | 1 | 1 | 1 | 2 | 3 | 1 | 0 | 3 | 3 | 0 | 9 | 28 | 5 | 14 | 22 | 12 |
| Bud Site | 1 | 1 | 1 | 0 | 1 | 0 | 0 | 1 | 0 | 1 | 0 | 0 | 2 | 0 | 0 | 0 | 0 | 0 | – | – | – | – | – | – |
| Cell Periphery | 2 | 4 | 1 | 3 | 1 | 0 | 0 | 2 | 0 | 0 | 1 | 0 | 1 | 1 | 2 | 3 | 1 | 4 | 0 | 3 | 5 | 2 | 5 | 6 |
| Cytoplasm | 62 | 272 | 141 | 118 | 143 | 113 | 155 | 195 | 137 | 182 | 147 | 163 | 325 | 222 | 240 | 413 | 321 | 272 | 21 | 112 | 41 | 54 | 110 | 164 |
| Endoplasmic Reticulum | 7 | 6 | 4 | 0 | 4 | 2 | 3 | 0 | 1 | 0 | 0 | 0 | 2 | 0 | 1 | 33 | 14 | 20 | 2 | 3 | 1 | 1 | 10 | 5 |
| Endosome | 0 | 0 | 0 | 0 | 0 | 0 | 0 | 0 | 0 | 0 | 0 | 0 | 0 | 3 | 0 | 6 | 2 | 5 | 5 | 8 | 4 | 1 | 5 | 3 |
| Golgi | 0 | 1 | 0 | 0 | 0 | 0 | 0 | 0 | 0 | 0 | 0 | 0 | 1 | 0 | 0 | 2 | 1 | 0 | 2 | 1 | 1 | 0 | 2 | 1 |
| Mitochondria | 1 | 6 | 6 | 6 | 8 | 28 | 28 | 20 | 8 | 20 | 18 | 30 | 1 | 0 | 1 | 10 | 1 | 7 | 5 | 12 | 24 | 8 | 18 | 13 |
| Nucleus | 0 | 0 | 0 | 1 | 3 | 2 | 5 | 3 | 0 | 1 | 1 | 0 | 0 | 1 | 0 | 11 | 4 | 5 | 0 | 0 | 0 | 0 | 0 | 0 |
| Nuclear Periphery | 0 | 0 | 1 | 0 | 0 | 0 | 0 | 0 | 0 | 0 | 0 | 0 | 0 | 0 | 0 | 0 | 1 | 0 | 0 | 0 | 0 | 0 | 0 | 0 |
| Nucleolus | 0 | 0 | 0 | 0 | 0 | 0 | 0 | 1 | 0 | 0 | 0 | 0 | 0 | 0 | 0 | 1 | 1 | 1 | 0 | 0 | 0 | 0 | 0 | 0 |
| Peroxisomes | 0 | 0 | 0 | 0 | 0 | 0 | 0 | 0 | 0 | 1 | 0 | 0 | 1 | 1 | 0 | 0 | 1 | 0 | 0 | 0 | 0 | 0 | 0 | 0 |
| SpindlePole | 0 | 2 | 2 | 0 | 0 | 1 | 0 | 0 | 0 | 0 | 1 | 0 | 3 | 0 | 0 | 3 | 5 | 6 | 0 | 2 | 2 | 0 | 3 | 1 |
| Vac/Vac Membrane | 0 | 14 | 0 | 1 | 8 | 8 | 8 | 5 | 2 | 3 | 2 | 5 | 1 | 0 | 0 | 64 | 63 | 44 | 39 | 122 | 39 | 31 | 61 | 61 |
| Unique Cell Count | 73 | 299 | 153 | 122 | 162 | 140 | 182 | 211 | 142 | 193 | 156 | 179 | 338 | 228 | 242 | 475 | 377 | 317 | 95 | 333 | 140 | 138 | 278 | 294 |
| Labelled Cell Count | 78 | 316 | 163 | 131 | 175 | 157 | 206 | 240 | 154 | 213 | 175 | 204 | 350 | 232 | 244 | 550 | 419 | 364 | 95 | 333 | 140 | 138 | 278 | 294 |
Yeast GFP Assignment
Protein Abundance
| Screen | WT1 | WT2 | WT3 | RAP60 | RAP140 | RAP220 | RAP300 | RAP380 | RAP460 | RAP540 | RAP620 | RAP700 | HU80 | HU120 | HU160 | rpd3Δ_1 | rpd3Δ_2 | rpd3Δ_3 | AF100 | AF140 | AF180 |
|---|---|---|---|---|---|---|---|---|---|---|---|---|---|---|---|---|---|---|---|---|---|
| Mean Cell GFP Intensity (1e-4) | 5.3 | 4.1 | 3.1 | 3.1 | 3.5 | 3.3 | 3.2 | 3.4 | 3.3 | 2.8 | 3.0 | 2.6 | 4.3 | 4.2 | 3.8 | 6.3 | 6.7 | 6.6 | 4.4 | 4.4 | 5.0 |
| Std Deviation (1e-4) | 1.1 | 0.8 | 0.6 | 0.9 | 1.2 | 0.8 | 1.0 | 1.1 | 1.8 | 1.3 | 1.2 | 0.8 | 0.9 | 0.9 | 0.9 | 1.7 | 2.2 | 2.5 | 1.0 | 1.3 | 1.4 |
| Intensity Change (Log2) | – | – | – | -0.02 | 0.19 | 0.1 | 0.04 | 0.11 | 0.07 | -0.12 | -0.06 | -0.23 | 0.46 | 0.44 | 0.28 | 1.01 | 1.11 | 1.09 | 0.49 | 0.51 | 0.68 |
Localization Change
| Localization | RAP60 | RAP140 | RAP220 | RAP300 | RAP380 | RAP460 | RAP540 | RAP620 | RAP700 | HU80 | HU120 | HU160 | rpd3Δ_1 | rpd3Δ_2 | rpd3Δ_3 |
|---|---|---|---|---|---|---|---|---|---|---|---|---|---|---|---|
| Actin | – | – | – | – | – | – | – | – | – | – | – | – | – | – | – |
| Bud | – | – | – | – | – | – | – | – | – | – | – | – | 0 | 0 | 0 |
| Bud Neck | – | – | – | – | – | – | – | – | – | – | – | – | 0 | 0 | 0 |
| Bud Site | – | – | – | – | – | – | – | – | – | – | – | – | 0 | 0 | 0 |
| Cell Periphery | – | – | – | – | – | – | – | – | – | – | – | – | 0 | 0 | 0 |
| Cyto | – | – | – | – | – | – | – | – | – | – | – | – | – | – | – |
| Endoplasmic Reticulum | – | – | – | – | – | – | – | – | – | – | – | – | 0 | 0 | 0 |
| Endosome | – | – | – | – | – | – | – | – | – | – | – | – | 0 | 0 | 0 |
| Golgi | – | – | – | – | – | – | – | – | – | – | – | – | 0 | 0 | 0 |
| Mitochondria | – | – | – | – | – | – | – | – | – | – | – | – | 0 | 0 | 0 |
| Nuclear Periphery | – | – | – | – | – | – | – | – | – | – | – | – | 0 | 0 | 0 |
| Nuc | – | – | – | – | – | – | – | – | – | – | – | – | – | – | – |
| Nucleolus | – | – | – | – | – | – | – | – | – | – | – | – | 0 | 0 | 0 |
| Peroxisomes | – | – | – | – | – | – | – | – | – | – | – | – | 0 | 0 | 0 |
| SpindlePole | – | – | – | – | – | – | – | – | – | – | – | – | 0 | 0 | 0 |
| Vac | – | – | – | – | – | – | – | – | – | – | – | – | – | – | – |
| Cortical Patches | – | – | – | – | – | – | – | – | – | – | – | – | 0 | 0 | 0 |
| Cytoplasm | – | – | – | – | – | – | – | – | – | – | – | – | 0 | 0 | 0 |
| Nucleus | – | – | – | – | – | – | – | – | – | – | – | – | 0 | 0 | 0 |
| Vacuole | – | – | – | – | – | – | – | – | – | – | – | – | 4.8 | 5.4 | 4.8 |
External localization resources
Images






























Protein Concentration and Protein Localization Data
| R1 | R2 | R3 | ||||||||||||||||
|---|---|---|---|---|---|---|---|---|---|---|---|---|---|---|---|---|---|---|
| G1 Pre-START | G1 Post-START | S/G2 | Metaphase | Anaphase | Telophase | G1 Pre-START | G1 Post-START | S/G2 | Metaphase | Anaphase | Telophase | G1 Pre-START | G1 Post-START | S/G2 | Metaphase | Anaphase | Telophase | |
| Concentration | 1.2178 | 0.1035 | -0.2639 | -0.3198 | -0.4812 | 0.3327 | 1.9714 | 1.9879 | 1.3652 | 1.8043 | 2.6201 | 1.7737 | 2.8496 | 2.704 | 2.6431 | 2.8858 | 2.5133 | 2.913 |
| Actin | 0.0724 | 0.0015 | 0.0001 | 0.0198 | 0.0163 | 0.0189 | 0.0281 | 0.0003 | 0.0037 | 0.0003 | 0.0305 | 0.0023 | 0 | 0.001 | 0 | 0.0014 | 0.0003 | 0.0001 |
| Bud | 0.0037 | 0.001 | 0.0015 | 0.0062 | 0.0004 | 0.0005 | 0.0007 | 0.0029 | 0.0025 | 0.0003 | 0.0011 | 0.001 | 0.0001 | 0.0075 | 0.0001 | 0.0002 | 0.0012 | 0.0002 |
| Bud Neck | 0.0186 | 0.0004 | 0.0003 | 0.0024 | 0.0007 | 0.0014 | 0.0022 | 0.0001 | 0.0069 | 0.0001 | 0.0039 | 0.0009 | 0.0004 | 0.0003 | 0 | 0.0001 | 0.0001 | 0.0117 |
| Bud Periphery | 0.0074 | 0.0017 | 0.0017 | 0.0228 | 0.0007 | 0.0012 | 0.0014 | 0.0032 | 0.0029 | 0.0006 | 0.0013 | 0.0013 | 0.0002 | 0.0089 | 0.0001 | 0.0003 | 0.001 | 0.0002 |
| Bud Site | 0.0148 | 0.0054 | 0.0003 | 0.0024 | 0.0009 | 0.0006 | 0.0062 | 0.0019 | 0.0045 | 0.0002 | 0.0054 | 0.0005 | 0.0007 | 0.0079 | 0.0001 | 0.0002 | 0.0001 | 0.0001 |
| Cell Periphery | 0.0034 | 0.001 | 0.0003 | 0.001 | 0.0002 | 0.0002 | 0.0006 | 0.0004 | 0.0005 | 0.0003 | 0.0003 | 0.0002 | 0.001 | 0.0008 | 0.0001 | 0.0001 | 0.0001 | 0.0002 |
| Cytoplasm | 0.155 | 0.2425 | 0.2534 | 0.153 | 0.3082 | 0.3337 | 0.1117 | 0.1169 | 0.1234 | 0.1554 | 0.1294 | 0.2315 | 0.0865 | 0.0813 | 0.0646 | 0.1452 | 0.0774 | 0.184 |
| Cytoplasmic Foci | 0.0628 | 0.0208 | 0.0382 | 0.0678 | 0.0177 | 0.0666 | 0.0311 | 0.0235 | 0.0214 | 0.0241 | 0.0181 | 0.0354 | 0.0241 | 0.0226 | 0.0081 | 0.0296 | 0.0052 | 0.0755 |
| Eisosomes | 0.0013 | 0.0002 | 0.0001 | 0.0004 | 0.0001 | 0.0003 | 0.0006 | 0.0001 | 0.0002 | 0 | 0.0004 | 0.0001 | 0.0001 | 0.0002 | 0.0001 | 0.0006 | 0.0003 | 0.0001 |
| Endoplasmic Reticulum | 0.0061 | 0.0045 | 0.0047 | 0.0064 | 0.0016 | 0.0045 | 0.0049 | 0.0019 | 0.0024 | 0.0013 | 0.0168 | 0.0018 | 0.0017 | 0.0017 | 0.0009 | 0.0016 | 0.0004 | 0.0022 |
| Endosome | 0.0541 | 0.0138 | 0.038 | 0.0483 | 0.0189 | 0.0571 | 0.0365 | 0.0166 | 0.0241 | 0.028 | 0.0803 | 0.0112 | 0.0289 | 0.0078 | 0.008 | 0.0252 | 0.0002 | 0.0571 |
| Golgi | 0.0169 | 0.0009 | 0.0007 | 0.006 | 0.0098 | 0.0089 | 0.0033 | 0.0004 | 0.0016 | 0.0019 | 0.0155 | 0.0014 | 0.0005 | 0.0006 | 0.0002 | 0.0006 | 0.0001 | 0.0014 |
| Lipid Particles | 0.036 | 0.006 | 0.0088 | 0.0096 | 0.0112 | 0.0129 | 0.0076 | 0.0021 | 0.0053 | 0.0337 | 0.015 | 0.0017 | 0.0026 | 0.0027 | 0.0004 | 0.0012 | 0.0003 | 0.0027 |
| Mitochondria | 0.0377 | 0.0009 | 0.0009 | 0.0202 | 0.0081 | 0.0157 | 0.0029 | 0.0007 | 0.0014 | 0.0014 | 0.0058 | 0.0013 | 0.001 | 0.0017 | 0.0003 | 0.0016 | 0.0003 | 0.0017 |
| None | 0.4133 | 0.6767 | 0.6351 | 0.5465 | 0.5663 | 0.4309 | 0.6823 | 0.8197 | 0.7818 | 0.6913 | 0.5691 | 0.6931 | 0.8077 | 0.8232 | 0.9065 | 0.772 | 0.9019 | 0.6441 |
| Nuclear Periphery | 0.0168 | 0.0011 | 0.0012 | 0.0084 | 0.0015 | 0.0126 | 0.0182 | 0.0006 | 0.001 | 0.003 | 0.0516 | 0.0019 | 0.0004 | 0.0006 | 0.0004 | 0.0009 | 0.0008 | 0.0006 |
| Nucleolus | 0.004 | 0.0005 | 0.0004 | 0.0006 | 0.0003 | 0.0009 | 0.0021 | 0.0003 | 0.0005 | 0.0016 | 0.0016 | 0.0007 | 0.0006 | 0.0017 | 0.0001 | 0.0003 | 0.0006 | 0.0003 |
| Nucleus | 0.0053 | 0.0016 | 0.0015 | 0.0026 | 0.001 | 0.0047 | 0.0148 | 0.0008 | 0.0012 | 0.0349 | 0.0209 | 0.002 | 0.0009 | 0.0023 | 0.0006 | 0.0009 | 0.0022 | 0.001 |
| Peroxisomes | 0.0261 | 0.0059 | 0.0006 | 0.0056 | 0.0031 | 0.0034 | 0.0077 | 0.0003 | 0.0016 | 0.0036 | 0.0045 | 0.0041 | 0.0002 | 0.0013 | 0.0001 | 0.001 | 0.0001 | 0.0015 |
| Punctate Nuclear | 0.0057 | 0.0009 | 0.0016 | 0.0044 | 0.0012 | 0.01 | 0.0222 | 0.0005 | 0.0019 | 0.0079 | 0.0134 | 0.0026 | 0.0003 | 0.0014 | 0.0002 | 0.0006 | 0.0069 | 0.0007 |
| Vacuole | 0.0347 | 0.0122 | 0.0093 | 0.0404 | 0.0294 | 0.0124 | 0.0128 | 0.0062 | 0.0103 | 0.0091 | 0.0104 | 0.0043 | 0.0412 | 0.0218 | 0.0081 | 0.0141 | 0.0005 | 0.0129 |
| Vacuole Periphery | 0.0039 | 0.0007 | 0.0013 | 0.0254 | 0.0024 | 0.0024 | 0.002 | 0.0005 | 0.001 | 0.0011 | 0.0048 | 0.0007 | 0.001 | 0.0026 | 0.0009 | 0.0021 | 0.0001 | 0.0016 |
Sequencing Data
| R1 | R2 | |||||||||
|---|---|---|---|---|---|---|---|---|---|---|
| G1 Post-START | S/G2 | Metaphase | Anaphase | Telophase | G1 Post-START | S/G2 | Metaphase | Anaphase | Telophase | |
| Gene Expression | 5.7572 | 5.8818 | 42.9907 | 191.9225 | 81.8955 | 2.6304 | 6.9135 | 10.3357 | 93.8654 | 161.3306 |
| Translational Efficiency | – | – | – | – | – | – | – | – | – | – |
Hit Data
| Dataset | Hit |
|---|---|
| Protein Concentration | ✔ |
| Protein Localization | ✘ |
| Gene Expression | ✔ |
| Translational Efficiency | – |
Endocytosis
| Temp | Actin Patch (Sac6-tdTomato) | Cortical Patch (Sla1-GFP) | Late Endosome (Snf7-GFP) | Vacuole (Vph1-GFP) |
|---|---|---|---|---|
| 37℃ | ||||
| RT |
Cell Cycle Omics
CYCLoPs (Dse4-GFP)
| Gene / Allele | Actin Patch (Sac6-tdTomato) | Cortical Patch (Sla1-GFP) | Late Endosome (Snf7-GFP) | Vacuole (Sac6-tdTomato) |
|---|
| Gene | Images |
|---|
| Gene | Images |
|---|
Images are not yet available
Images are not yet available